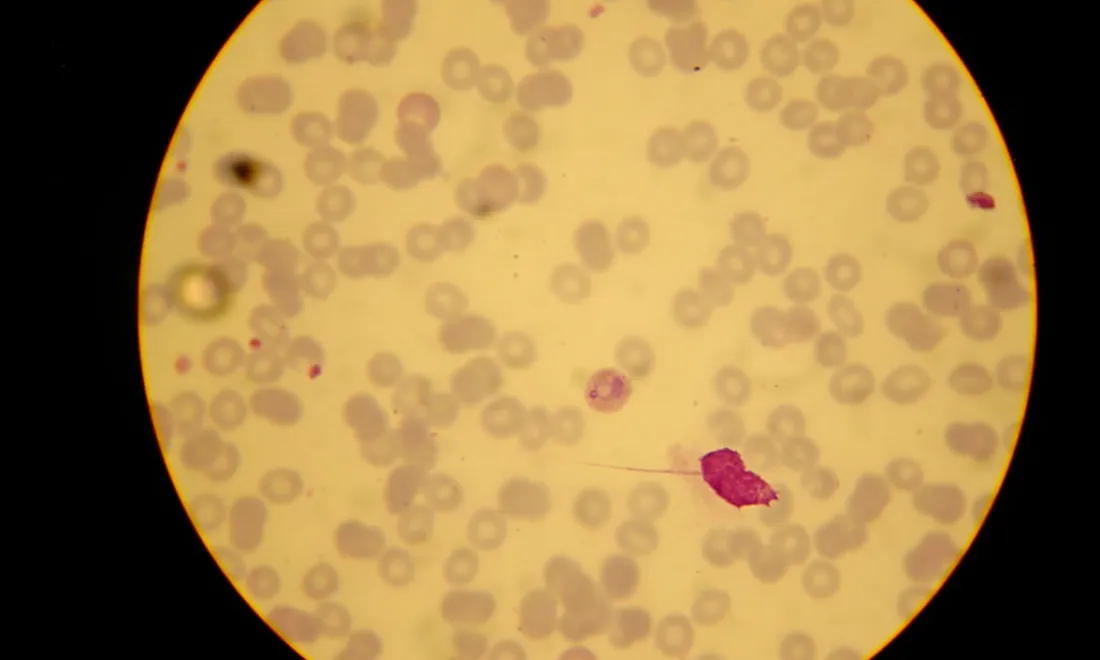
p vivax

Literature Reviews
WWARN literature reviews are a valuable resource for researchers when developing a malaria research project. These comprehensive publication reviews and databases are a reference tool to identify gaps in published clinical and pharmacological data, consider publication trends over time review the different study approaches and methodology, and identify relevant clinical study results which might contribute trial patient information for further pooled analyses.

i
Credit-shehan-peruma-flickr